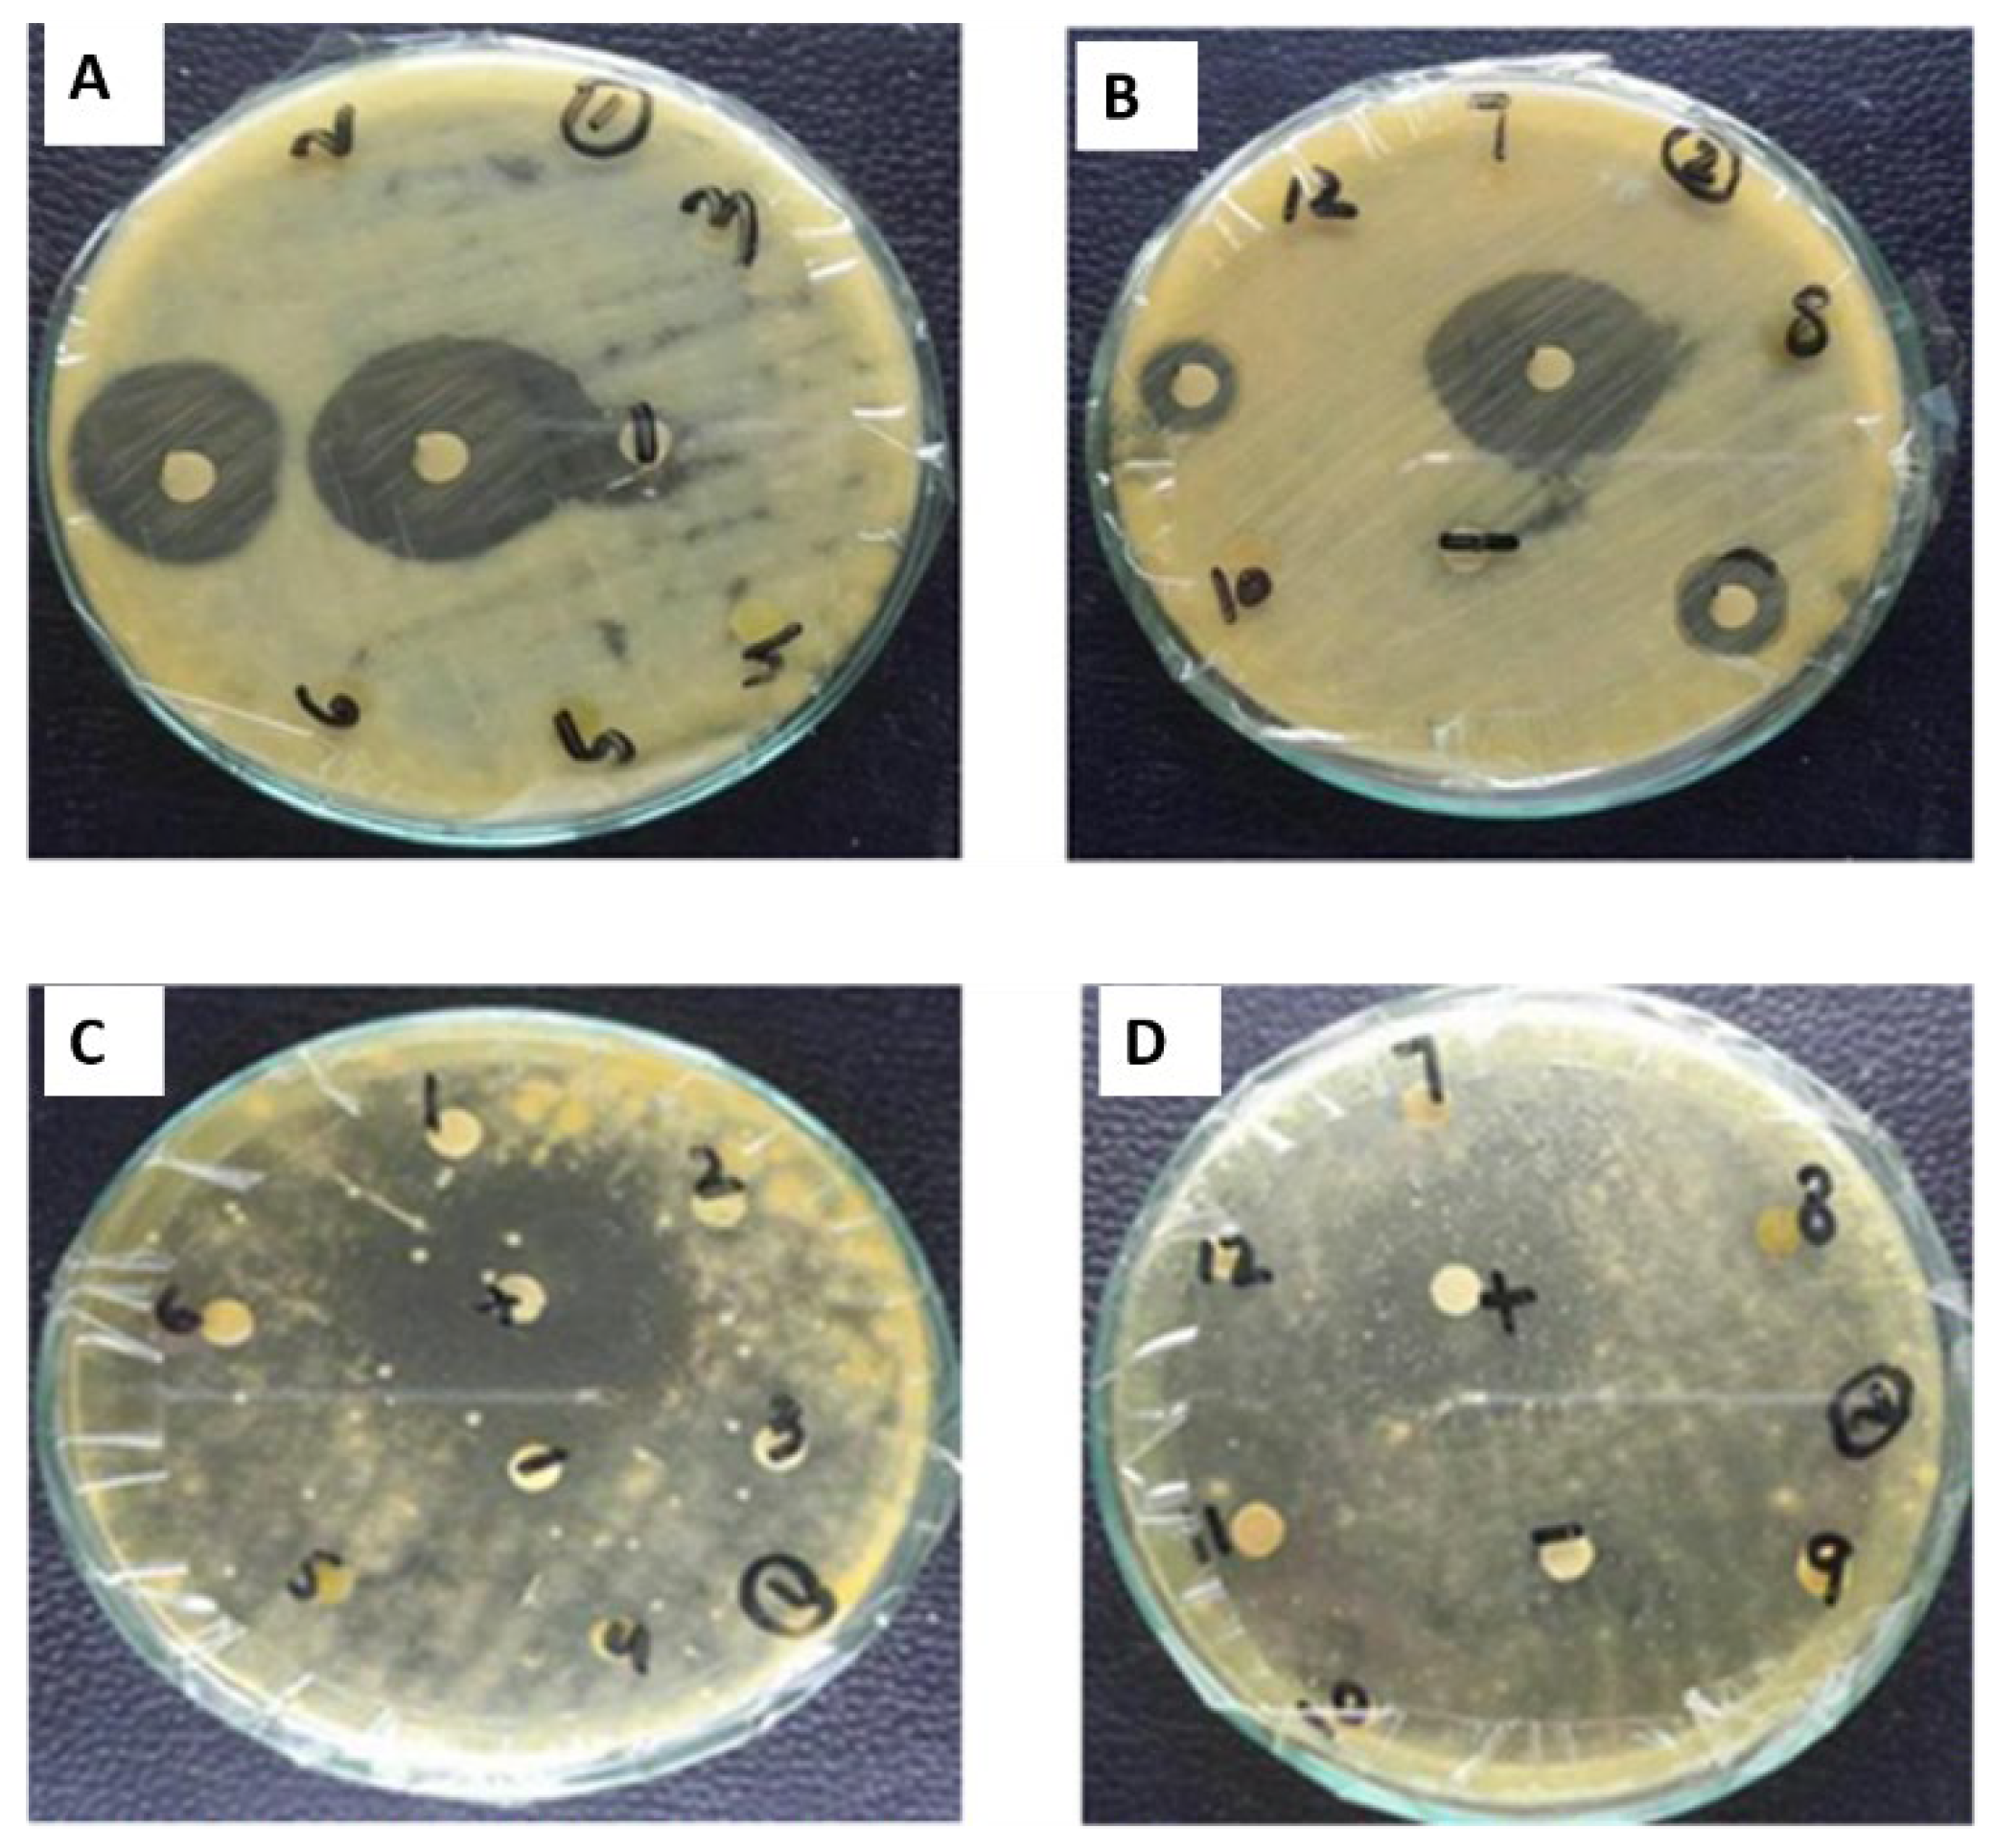
Plants 11 01525 g012

Comparative Evaluation of Biomedical Applications of Zinc Nanoparticles Synthesized by Using Withania somnifera Plant Extracts
Abstract
:1. Introduction
2. Results
2.1. Extract Recovery
2.2. Synthesis of Zinc Oxide Nanaoparticles
2.3. Characterization of Zinc Nanoparticles
2.4. Phytochemical Analysis
2.4.1. Total Phenolic Contents
2.4.2. Total Flavonoid Contents
2.4.3. Total Alkaloid Contents
2.5. Biological Activities
2.5.1. Antioxidant Assay
2.5.2. Antibacterial Assay
2.5.3. Antifungal Assay
2.5.4. Cytotoxicity Activity
2.6. Enzyme Inhibition Assays
2.6.1. Protein Kinase
2.6.2. α-Amylase Inhibition Assay
3. Discussion
4. Materials and Methods
4.1. Plant Sample Collection and Identification
4.2. Plant Extract Formulation
4.3. Synthesis of Zinc Oxide Nanoparticles (ZnONPs)
4.4. Characterization of Zinc Oxide Nanoparticles
4.4.1. UV-Visible Spectroscopy
4.4.2. Scanning Electron Microscopy Analysis (SEM)
4.5. X-ray Diffraction Analysis (XRD)
4.6. Phytochemical Analysis
4.6.1. Total Flavonoid Concentration Assessment
4.6.2. Total Phenolic Concentration Assessment
4.6.3. Total Alkaloids Determination
4.7. Biological Activities
4.7.1. Antibacterial Assay
4.7.2. Antifungal Assay
4.7.3. Brine Shrimp Cytotoxicity Assay
4.7.4. Free Radical Scavenging Property
4.8. Enzyme Inhibition Assays
4.8.1. Protein Kinase Assay
4.8.2. α-Amylase Inhibition Assay
4.9. Statistical Analysis
5. Conclusions
Author Contributions
Funding
Institutional Review Board Statement
Informed Consent Statement
Data Availability Statement
Acknowledgments
Conflicts of Interest
References
- Skrovankova, S.; Misurcova, L.; Macha, L. Antioxidant activity and protecting health effects of common medicinal plants. In Advances in Food and Nutrition Research; Elsevier: Amsterdam, The Netherlands, 2012; pp. 75–139. [Google Scholar]
- Ortega, A.M.M.; Campos, M.R.S. Bioactive Compounds as Therapeutic Alternatives. In Bioactive Compounds; Elsevier: Amsterdam, The Netherlands, 2019; pp. 247–264. [Google Scholar]
- Bandhan, B.K.; Panigrahi, A.K. Green synthesis and characterization of gold nanoparticles using leaf extracts of Withania somnifera (Linn.) (Ashwagandha). Int. J. Mater. Sci. Appl. 2014, 3, 279–284. [Google Scholar] [CrossRef]
- Raut, R.W.; Mendhulkar, V.D.; Kashid, S.B. Photosensitized synthesis of silver nanoparticles using Withania somnifera leaf powder and silver nitrate. J. Photochem. Photobiol. B Biol. 2014, 132, 45–55. [Google Scholar] [CrossRef] [PubMed]
- Marslin, G.; Selvakesavan, R.K.; Franklin, G.; Sarmento, B.; Dias, A.C. Antimicrobial activity of cream incorporated with silver nanoparticles biosynthesized from Withania somnifera. Int. J. Nanomed. 2015, 10, 5955–5963. [Google Scholar]
- Chauhan, N.B.; Mehla, J. Ameliorative Effects of Nutraceuticals in Neurological Disorders. In Bioactive Nutraceuticals and Dietary Supplements in Neurological and Brain Disease; Elsevier: Amsterdam, The Netherlands, 2015; pp. 245–260. [Google Scholar]
- John, J. Therapeutic potential of Withania somnifera: A report on phyto-pharmacological properties. Int. J. Pharm. Sci. Res. 2014, 5, 2131–2148. [Google Scholar]
- Chatterjee, S.; Srivastava, S.; Khalid, A.; Singh, N.; Sangwan, R.S.; Sidhu, O.P.; Roy, R.; Khetrapal, C.; Tuli, R. Comprehensive metabolic fingerprinting of Withania somnifera leaf and root extracts. Phytochemistry 2010, 71, 1085–1094. [Google Scholar] [CrossRef] [PubMed]
- Caruthers, S.D.; Wickline, S.A.; Lanza, G.M. Nano technological applications in medicine. Curr. Opin. Biotechnol. 2007, 18, 26–30. [Google Scholar] [CrossRef]
- Kuppusamy, P.; Yusoff, M.M.; Maniam, G.P.; Govindan, N. Biosynthesis of metallic nanoparticles using plant derivatives and their new avenues in pharmacological applications–An updated report. Saudi Pharm. J. 2016, 24, 473–484. [Google Scholar] [CrossRef]
- Varghese, E.; George, M. Green synthesis of zinc oxide nanoparticles. Int. J. Adv. Res. Sci. Eng. 2015, 4, 307–314. [Google Scholar]
- Dobrucka, R.; Długaszewska, J. Biosynthesis and antibacterial activity of ZnO nanoparticles using Trifolium pratense flower extract. Saudi J. Biol. Sci. 2016, 23, 517–523. [Google Scholar] [CrossRef] [Green Version]
- Agarwal, H.; Kumar, S.V.; Rajeshkumar, S. A review on green synthesis of zinc oxide nanoparticles—An eco-friendly approach. Resour. Effic. Technol. 2017, 3, 406–413. [Google Scholar] [CrossRef]
- Aboyewa, J.A.; Sibuyi, N.; Meyer, M.; Oguntibeju, O.O. Green Synthesis of Metallic Nanoparticles Using Some Selected Medicinal Plants from Southern Africa and Their Biological Applications. Plants 2021, 10, 1929. [Google Scholar] [CrossRef]
- Buazar, F.; Bavi, M.; Kroushawi, F.; Halvani, M.; Khaledi-Nasab, A.; Hosseini, S.A. Potato extract as reducing agent and stabilizer in a facile green one-step synthesis of ZnO nanoparticles. J. Exp. Nanosci. 2016, 11, 175–184. [Google Scholar] [CrossRef] [Green Version]
- Iravani, S. Green synthesis of metal nanoparticles using plants. Green Chem. 2011, 13, 2638–2650. [Google Scholar] [CrossRef]
- Ahmed, S.; Chaudhry, S.A.; Ikram, S. A review on biogenic synthesis of ZnO nanoparticles using plant extracts and microbes: A prospect towards green chemistry. J. Photochem. Photobiol. B Biol. 2017, 166, 272–284. [Google Scholar] [CrossRef] [PubMed]
- Fakhari, S.; Jamzad, M.; Kabiri, F.H. Green synthesis of zinc oxide nanoparticles: A comparison. Green Chem. Lett. Rev. 2019, 12, 19–24. [Google Scholar] [CrossRef] [Green Version]
- Dahoumane, S.; Mechouet, M.; Wijesekera, K.; Filipe, C.D.M.; Cicard, C.; Bazylinski, D.A.; Jeffryes, C.A. Algae-mediated biosynthesis of inorganic nanomaterials as a promising route in nanobiotechnology—A review. Green Chem. 2017, 19, 552–587. [Google Scholar] [CrossRef]
- Mahgoub, H.A. Nanoparticles used ZnONPs for extraction of polycyclic aromatic hydrocarbons. J. Cem. 2019, 2019, 4816849. [Google Scholar]
- Shinwari, Z.K.; Qaiser, M. Efforts on conservation and sustainable use of medicinal plants of Pakistan. Pak. J. Bot 2011, 43, 5–10. [Google Scholar]
- Bhattacharya, S.; Muruganandam, A. Adaptogenic activity of Withania somnifera: An experimental study using a rat model of chronic stress. Pharmacol. Biochem. Behav. 2003, 75, 547–555. [Google Scholar] [CrossRef]
- Raveesha, H.; Nayana, S.; Vasudha, D.; Begum, J.S.; Pratibha, S.; Ravikumara, C.; Dhananjaya, N. The electrochemical behavior, antifungal and cytotoxic activities of phytofabricated MgO nanoparticles using Withania somnifera leaf extract. J. Sci. Adv. Mater. Devices 2019, 4, 57–65. [Google Scholar] [CrossRef]
- Ramesh, M.; Anbuvannan, M.; Viruthagiri, G. Green synthesis of ZnO nanoparticles using Solanum nigrum leaf extract and their antibacterial activity. Spectrochim. Acta Part A Mol. Biomol. Spectrosc. 2015, 136, 864–870. [Google Scholar] [CrossRef]
- Jayaprakasam, B.; Zhang, Y.; Seeram, N.P.; Nair, M.G. Growth inhibition of human tumor cell lines by withanolides from Withania somnifera leaves. Life Sci. 2003, 74, 125–132. [Google Scholar] [CrossRef] [PubMed]
- Jamdagni, P.; Khatri, P.; Rana, J. Green synthesis of zinc oxide nanoparticles using flower extract of Nyctanthes arbor-tristis and their antifungal activity. J. King Saud Univ. Sci. 2018, 30, 168–175. [Google Scholar] [CrossRef] [Green Version]
- Uddin, M.K.; Juraimi, A.S.; Ali, M.E.; Ismail, M.R. Evaluation of antioxidant properties and mineral composition of purslane (Portulaca oleracea L.) at die rent growth stages. Int. J. Mol. Sci. 2012, 13, 10257–10267. [Google Scholar] [CrossRef]
- Burri, S.C.M.; Ekholm, A.; Håkansson, Å.; Tornberg, E.; Rumpunen, K. Antioxidant capacity and major phenol compounds of horticultural plant materials not usually used. J. Funct. Foods 2017, 38, 119–127. [Google Scholar] [CrossRef] [PubMed]
- Alagesan, V.; Venugopal, S. Green Synthesis of Selenium Nanoparticle Using Leaves Extract of Withania somnifera and Its Biological Applications and Photocatalytic Activities. Bionanoscience 2019, 9, 105–116. [Google Scholar] [CrossRef] [Green Version]
- Al-Dhabi, N.; Valan, A.M. Environmentally-friendly green approach for the production of zinc oxide nanoparticles and their anti-fungal, ovicidal, and larvicidal properties. Nanomaterials 2018, 8, 500–509. [Google Scholar] [CrossRef] [Green Version]
- Singh, G.; Sharma, P.; Dudhe, R.; Singh, S. Biological activities of Withania somnifera. Ann. Biol. Res. 2010, 1, 56–63. [Google Scholar]
- Adebooye, O.C.; Vijayalakshmi, R.; Singh, V. Peroxidase activity, chlorophylls and antioxidant profile of two leaf vegetables (Solanum nigrum L. and Amaranthus cruentus L.) under six pretreatment methods before cooking. Int. J. Food Sci. Technol. 2008, 43, 173–178. [Google Scholar] [CrossRef]
- Yen, G.C.; Chuang, D.Y. Antioxidant properties of water extracts from (Cassia tora L.) in relation to the degree of roasting. J. Agric. Food Chem. 2000, 48, 2760–2765. [Google Scholar] [CrossRef]
- Parry, J.; Su, L.; Luther, M.; Zhou, K.Q.; Yurawecz, M.P.; Whittaker, P. Fatty acid composition and antioxidant properties of cold-pressed marion berry, boysenberry, red raspberry, and blueberry seed oils. J. Agric. Food. Chem. 2005, 53, 566–573. [Google Scholar] [CrossRef] [PubMed]
- Huang, D.J.; Ou, B.X.; Prior, R.L. The chemistry behind antioxidant capacity assays. J. Agric. Food Chem. 2012, 53, 1841–1856. [Google Scholar] [CrossRef]
- Prior, R.L.; Wu, X.; Schaich, K. Standardized methods for the determination of antioxidant capacity and phenolics in foods and dietary supplements. J. Agric. Food Chem. 2005, 53, 4290–4302. [Google Scholar] [CrossRef]
- Zhou, K.Q.; Yin, J.J.; Yu, L.L. Phenolic acid, tochopherol and carotenoid compositions, and antioxidant functions of hard red winter wheat bran. J. Agr. Food Chem. 2005, 53, 3916–3922. [Google Scholar] [CrossRef] [PubMed]
- Sadighara, A.; Parisa, S.; Moghadam, A.J.; Golamreza, J.; Nabi, S.; Akbar, A.L. Potential therapeutic effects of (Morus alba) leaf extract on modulation oxidative damages induced by hyperglycemia in cultured fetus fibroblast cells. Glob. Vet. 2013, 10, 456–467. [Google Scholar]
- Ghagane, S.C.; Puranik, S.I.; Kumbar, V.M.; Nerli, R.B.; Jalalpure, S.S.; Hiremath, M.B. In vitro antioxidant and anticancer activity of (lee indica) leaf extracts on human prostate cancer cell lines. Integr. Med. Res. 2017, 6, 79–87. [Google Scholar] [CrossRef]
- Dildar, A.; Ramsha, S.; Nasir, S.; Khaizran, F.; Aneela, A. Antimicrobial activities of methanolic extract of Carissa opaca roots and its fractions and compounds isolated from the most active ethyl acetate fraction. Asian Pac. J. Trop. Biomed. 2015, 5, 541–545. [Google Scholar]
- Pal, S.; Tak, Y.K.; Song, J.M. Does the Antibacterial Activity of Silver Nanoparticles Depend on the Shape of the Nanoparticle? A Study of the Gram-Negative Bacterium (Escherichia coli). Appl. Environ. Microbiol. 2007, 73, 1712–1720. [Google Scholar] [CrossRef] [Green Version]
- Nade, V.S.L.; Kawale, A.; Bhangale, S.; Wale, Y. Cardioprotective and antihypertensive potential of Morus alba L.) in isoproterenol-induced myocardial infarction and renal artery ligation- induced hypertension. J. Nat. Remedies 2013, 1, 54–67. [Google Scholar]
- Paul, M.K.; Mukhopadhyay, A.K. Tyrosine kinase—Role and significance in Cancer. Int. J. Med. Sci. 2004, 1, 101–115. [Google Scholar] [CrossRef] [PubMed] [Green Version]
- Zahra, S.S.; Ahmed, M.; Qasim, M.; Gul, B.; Zia, M.; Mirza, B. Polarity based characterization of biologically active extracts of Ajuga bracteosa Wall ex. Benth and RP-HPLC analysis. BMC Complement Altern. Med. 2017, 17, 443. [Google Scholar] [CrossRef] [Green Version]
- Khan, I.; Saeed, K.; Khan, I. Nanoparticles: Properties, applications and toxicities. Arabian J. Chem. 2019, 12, 908–931. [Google Scholar] [CrossRef]
- Gunalana, S.; Sivaraja, R.; Rajendran, V. Green synthesized ZnO nanoparticles against bacterial and fungal pathogens. Prog. Nat. Sci. 2012, 22, 693–700. [Google Scholar] [CrossRef] [Green Version]
- Santosh, V.; Thakkar, S.; Kevin, M.; Allegre, S.B.; Joshi, D.B.; Volkin, C. Russell M. An application of ultraviolet spectroscopy to study interactions in proteins solutions at high concentrations. J. Pharm. Sci. 2012, 101, 3051–3061. [Google Scholar]
- Schaffer, B.; Hohenester, U.; Trugler, A.; Hofer, F. High resolution surface Plasmon imaging of gold nanoparticles by energy-filtered transmission electron microscopy. Phys. Rev. B 2009, 7, 9. [Google Scholar] [CrossRef] [Green Version]
- Haq, I.; Ullah, N.; Bibi, G.; Kanwal, S.; Ahmad, M.; Mirza, B. Antioxidant and Cytotoxic Activities and Phytochemical analysis of Root Extract and its Fractions. Iran. J. Pharm. Sci. 2012, 11, 241–249. [Google Scholar]
- Ajanal, M.; Gundkalle, M.B.; Nayak, S.U. Estimation of total alkaloid in Chitrakadivati by UV-Spectrophotometer. Anc. Sci. Life 2012, 31, 198–201. [Google Scholar] [CrossRef]
- Fatima, H.; Khan, K.; Zia, M.; Ur-Rehman, T.; Mirza, B.; Ha, I.-U. Extraction optimization of medicinally important metabolites from Datura innoxia Mill.: An invitro biological and phyrochemical investigation. BMC Complement. Altern. Med. 2015, 15, 376. [Google Scholar] [CrossRef] [Green Version]
- Kim, J.S.; Kwon, C.S.; Sou, K.H. Inhibition of alpha glycosidase and amylase luteolin a flavonoid. Biosci. Biotechnol. Biochem. 2000, 64, 2458–2461. [Google Scholar] [CrossRef]

| Extract Codes | Percent Extract Recovery (% w/w) | |
|---|---|---|
| Roots | Leaves | |
| nH | 2.05 | 4.42 |
| EA | 6.54 | 8.87 |
| M | 12.72 | 14.87 |
| Aq | 17.91 | 19.78 |
| Extract Codes | Antibacterial Assay | |||||||||
|---|---|---|---|---|---|---|---|---|---|---|
| Diameter of Zone of Inhibition in mm (Mean ± SD) * (MIC: µg/mL) | ||||||||||
| S.A | MIC | B.S | MIC | P.A | MIC | K.P | MIC | E.C | MIC | |
| Leaf | ||||||||||
| nH | 9 ± 0.28 | - | 3 ± 0.3 | - | 5 ± 0.13 | - | 6 ± 0.87 | - | 6 ± 0.51 | - |
| EA | 10 ± 0.31 | - | 6 ± 0.5 | - | 6 ± 0.31 | - | 7 ± 0.35 | - | 9 ± 0.50 | - |
| M | 9 ± 0.36 | - | 10 ± 0.8 | 100 | 7 ± 0.10 | - | 9 ± 0.76 | - | 13 ± 0.50 | 100 |
| Aq | 11 ± 0.39 | - | 13 ± 0.5 | 100 | 7 ± 0.10 | - | 12 ± 0.17 | 100 | 16 ± 0.31 | 100 |
| Leaf (ZnONPs) | ||||||||||
| nH | 9 ± 0.7 | - | 7 ± 0.5 | 100 | 6 ± 0.31 | - | 7 ± 0.55 | - | 7 ± 0.31 | - |
| EA | 14 ± 0.3 | - | 9 ± 0.5 | 3.7 | 8 ± 0.15 | - | 11 ± 0.50 | - | 11 ± 0.76 | 3.7 |
| M | 14 ± 0.46 * | 100 | 13 ± 0.45 | 33.3 | 9 ± 0.21 | - | 14 ± 0.76 * | 100 | 20 ± 0.76 * | 100 |
| Aq | 16 ± 0.31 * | 100 | 18 ± 0.5 * | 100 | 11 ± 0.25 | - | 15 ± 0.61 | 100 | 23 ± 0.50 * | 33.3 |
| Root | ||||||||||
| nH | 5 ± 0.15 | - | 7 ± 0.7 | - | 5 ± 0.15 | - | 7 ± 0.50 | - | 8 ± 0.15 | - |
| EA | 10 ± 0.17 | - | 8 ± 0.5 | - | 5 ± 0.15 | - | 12 ± 0.58 | 33.3 | 10 ± 0.58 | - |
| M | 14 ± 0.31 | 100 | 12 ± 0.2 | 100 | 6 ± 0.25 | - | 9 ± 0.31 | - | 13 ± 0.5 | - |
| Aq | 9 ± 0.32 | - | 11 ± 0.3 | - | 7 ± 0.33 | - | 13 ± 0.29 | 33.3 | 16 ± 0.50 | 100 |
| Root (ZnONPs) | ||||||||||
| nH | 9 ± 0.9 | - | 9 ± 0.5 | 100 | 7 ± 0.31 | - | 7 ± 0.55 | - | 10 ± 0.41 | - |
| EA | 13 ± 0.12 | 100 | 9 ± 0.5 | 3.7 | 6 ± 0.55 | - | 21 ± 0.70 * | 33.3 | 14 ± 0.5 | 3.7 |
| M | 16 ± 0.36 | - | 13 ± 0.31 | 33.3 | 8 ± 0.21 | - | 16 ± 0.96 * | 100 | 16 ± 0.31 | 100 |
| Aq | 22 ± 0.51 * | 33.3 | 12 ± 0.5 | - | 9 ± 0.34 | - | 18 ± 0.61 * | 100 | 20 ± 0.86 * | 33.3 |
| Controls | ||||||||||
| Rox | 23 ± 0.54 | 1.11 | 17 ± 0.3 | 3.33 | -- | - | - | - | - | - |
| Cefix | - | - | - | - | 22 ± 0.89 * | 1.11 | 20 ± 1.2 | 1.11 | 20 ± 1.5 | 3.33 |
| DMSO | - | - | - | -- | - | - | - | - | - | |
| Extract Codes | Antifungal Assay | |||
|---|---|---|---|---|
| Diameter of Zone of Inhibition in mm (Mean ± SD) | ||||
| A. Flavus | A. fumigatus | Mucor sp. | F. solani | |
| Leaf | ||||
| nH | 9 ± 0.18 | - | - | - |
| EA | - | - | - | - |
| M | 11 ± 0.6 | - | - | - |
| Aq | - | - | - | |
| Leaf (ZnONPs) | ||||
| nH | 12 ± 0.4 * | - | - | - |
| EA | -- | - | - | - |
| M | 15 ± 0.2 * | - | - | - |
| Aq | - | - | - | - |
| Root | ||||
| nH | - | - | - | - |
| EA | - | - | - | - |
| M | - | - | - | 11 ± 0.89 |
| Aq | - | - | - | - |
| Root (ZnONPs) | ||||
| nH | - | - | - | - |
| EA | - | - | - | - |
| M | - | - | - | 14 ± 0.98 * |
| Aq | - | - | - | -- |
| Controls | ||||
| Clotrim | 20 ± 0.57 * | 24 ± 0.09 * | 27 ± 0.57 * | 28 ± 1.23 * |
| DMSO | - | - | - | - |
| Extract Codes | % Mortality (Concentration: µg/mL) | LC50 µg/ml | |||
|---|---|---|---|---|---|
| 200 | 100 | 50 | 25 | ||
| Leaf | |||||
| nH | 70 ± 10 * | 40 ± 7.5 * | 2 ± 11.5 * | 20 ± 0 * | 130.93 |
| EA | 100 ± 0 | 100 ± 0 | 50 ± 5.7 | 30 ± 0 | 39.52 |
| M | 100 ± 0 * | 40 ± 5.7 * | 40 ± 0 * | 30 ± 7.5 * | 88.51 |
| Aq | 100 ± 0 | 50 ± 0 | 0 ± 0 | 0 ± 0 | 100 |
| Leaf (ZnONPs) | |||||
| nH | 30 ± 0 | 30 ± 0 | 0 ± 0 | 0 ± 0 | >200 |
| EA | 100 ± 5.7 | 100 ± 0 | 70 ± 0 * | 60 ± 7.5 * | 20 |
| M | 30 ± 11.5 | 20 ± 0 | 10 ± 0 | 10 ± 5.7 | >200 |
| Aq | 100 ± 0 | 50 ± 0 | 30 ± 5.7 * | 20 ± 0 * | 93.1 |
| Roots | |||||
| nH | 60 ± 10 | 30 ± 7.5 | 1 ± 11.5 | 10 ± 0 | 125.93 * |
| EA | 100 ± 0 | 100 ± 0 * | 50 ± 5.7 | 30 ± 0 | 49.22 |
| M | 100 ± 0 * | 40 ± 5.7 * | 40 ± 0 * | 30 ± 7.5 * | 78.60 |
| Aq | 100 ± 0 | 50 ± 0 | 0 ± 0 | 0 ± 0 | 100 * |
| Roots (ZnONPs) | |||||
| nH | 100 ± 0 * | 100 ± 0 * | 70 ± 0 * | 70 ± 0 * | 18.84 |
| EA | 100 ± 7.5 | 90 ± 7.5 | 50 ± 0 | 40 ± 0 * | 55.5 |
| M | 30 ± 5.7 | 16 ± 0 | 16 ± 0 | 10 ± 0 | >200 * |
| Aq | 100 ± 0 | 100 ± 0 * | 0 ± 0 | 60 ± 0 * | 9.36 |
| Plant Name | Extracts Name | Samples | Zones | Activity |
|---|---|---|---|---|
| W. somnifera Leaves | nH | N | 6 | Bald |
| C | 7 | Clear | ||
| EA | N | 8 | Bald | |
| C | 7 | clear | ||
| M | N | 7 | Bald | |
| C | 5 | Bald | ||
| Aq | N | 8 | Bald | |
| C | 5 | Clear | ||
| W. somnifera Roots | nH | N | 10 | Bald |
| C | 5 | Clear | ||
| EA | N | 12 | Bald | |
| C | 5 | Clear | ||
| M | N | 10 | Bald | |
| C | 6 | Clear | ||
| Aq | N | 7 | Clear/Bald | |
| C | 7 | Clear/Bald |
Publisher’s Note: MDPI stays neutral with regard to jurisdictional claims in published maps and institutional affiliations. |
© 2022 by the authors. Licensee MDPI, Basel, Switzerland. This article is an open access article distributed under the terms and conditions of the Creative Commons Attribution (CC BY) license (https://creativecommons.org/licenses/by/4.0/).
Share and Cite
Kiani, B.H.; Haq, I.-u.-; Alhodaib, A.; Basheer, S.; Fatima, H.; Naz, I.; Ur-Rehman, T. Comparative Evaluation of Biomedical Applications of Zinc Nanoparticles Synthesized by Using Withania somnifera Plant Extracts. Plants 2022, 11, 1525. https://doi.org/10.3390/plants11121525
Kiani BH, Haq I-u-, Alhodaib A, Basheer S, Fatima H, Naz I, Ur-Rehman T. Comparative Evaluation of Biomedical Applications of Zinc Nanoparticles Synthesized by Using Withania somnifera Plant Extracts. Plants. 2022; 11(12):1525. https://doi.org/10.3390/plants11121525
Chicago/Turabian StyleKiani, Bushra Hafeez, Ihsan-ul- Haq, Aiyeshah Alhodaib, Samra Basheer, Humaira Fatima, Iffat Naz, and Tofeeq Ur-Rehman. 2022. "Comparative Evaluation of Biomedical Applications of Zinc Nanoparticles Synthesized by Using Withania somnifera Plant Extracts" Plants 11, no. 12: 1525. https://doi.org/10.3390/plants11121525
APA StyleKiani, B. H., Haq, I.-u.-, Alhodaib, A., Basheer, S., Fatima, H., Naz, I., & Ur-Rehman, T. (2022). Comparative Evaluation of Biomedical Applications of Zinc Nanoparticles Synthesized by Using Withania somnifera Plant Extracts. Plants, 11(12), 1525. https://doi.org/10.3390/plants11121525

